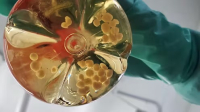

As the chances of President Donald Trumps peace deal in Ukraine seemingly recede, attention turns back to the question of Vladimir Putin and his war aims. What does the Russian president want to achieve from the conflict?...

The U.S. Food and Drug Administration is warning Americans about the ever-increasing and potentially deadly recreational use of nitrous oxide products, particularly among young people. Marketed with names like Galaxy Gas...

As the Class of 2025 graduates into an uncertain and fast-changing working world, they face a crucial question: What does it mean to be successful? Is it better to take a job that pays more, or one thats more prestigious?...
As the Trump administration continues to make significant cuts to NIH budgets and personnel and to freeze billions of dollars of funding to major research universities citing ideological concerns theres more being...

To fend off Reform, mainstream parties must address the tangible decline of British towns
Reform UKs surge in recent local elections is not an isolated incident but a culmination of long-term economic and social shifts that have reshaped British society. It is the latest chapter in a narrative that includes the...

The 2024 Sir Paul Curran award for academic journalism goes to Paul Whiteley
Paul Whiteley, emeritus professor of government at the University of Essex, has been named as the 2024 winner of the Sir Paul Curran award for academic communication. The prize is awarded every year to an academic who has...